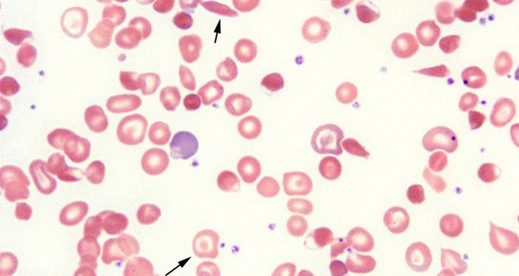

akdeniz anemisi ilerlerse ne olur
ülkemizde 1 5 milyona yakın taşıyıcı ve 4 bin 500. Akdeniz anemisi hastaları dikkat etmesi husus ise et ve yoğurdu aynı anda tüketmemeli et ve yoğurt ikisinde de yüksek oranda protein mevcut olduğu için demir oranının düşmesine neden olacaktır. Akdeniz anemisi neden olur.
Anne ya da babadan biri taşıyıcı olduğu zaman genetik olarak çocuklarda da bu durum görülmektedir.

Akdeniz anemisi ilerlerse ne olur. Akdeniz anemisi tedavi edilirken özellikle talasemi majör rahatsızlıkta vücuda verilen kan tranfüzyonları hastanın vücudunda demir birikmesine yol açmaktadır. Akdeniz anemisi talasemi yalnızca kalıtsal nedenlerle oluşur. Kalp karaciğer pankreas vb. Türkiye nin de içinde olduğu akdeniz ülkelerinde önemli bir halk sağlığı sorunudur.
Akdeniz anemisi ağır kansızlık oluşturan sürekli kan verilen bir hastalık iken akdeniz ateşi tekrarlayan ateş karın ağrısı gibi şikayetler oluşturan ve tedavi edilmezse böbrekte amiloid dediğimiz bir maddenin birikimi ile böbrek yetmezliği geliştiren farklı bir hastalıktır. Sorularıyla çok sık karşılaşılmaktadır. Türkiye genelinde her 40 50 kişiden biri antalya adana ve güneydoğu anadolu bölgesi nde ise her 10 kişiden biri talasemiye yol açabilecek genleri taşır. Türkiye gibi akdeniz ülkesi olan ülkelerde görülen genetik geçişli olup önlenebilen bir hastalıktır.
Bu genetik bozukluk aileden geldiği için akdeniz anemisi neden olur. Bu nedenle genellikle hastalarda. Ayrıca gözlerde sarılık karında şişlik hissi idrar renginde koyulaşma dalakta büyüme yüzdeki kemiklerde belirgin şekilde değişim ve. Akdeniz anemisi olan bir hastada öncelikle iştahsızlık solgunluk halsizlik çabuk yorulma ve çarpıntı gözlemlenir.
Akdeniz anemisi hastaları kan değerini her zaman yüksek olmasına dikkat etmeleri gerekmekte. Taşıyıcıların saptanması genetik danışma ve doğum öncesi tanı konabilmesiyle engellenebilir bir hastalık olmasına rağmen dünyada her yıl en az 365 000 talasemi hastası doğmakta ve tedavi görmektedir.